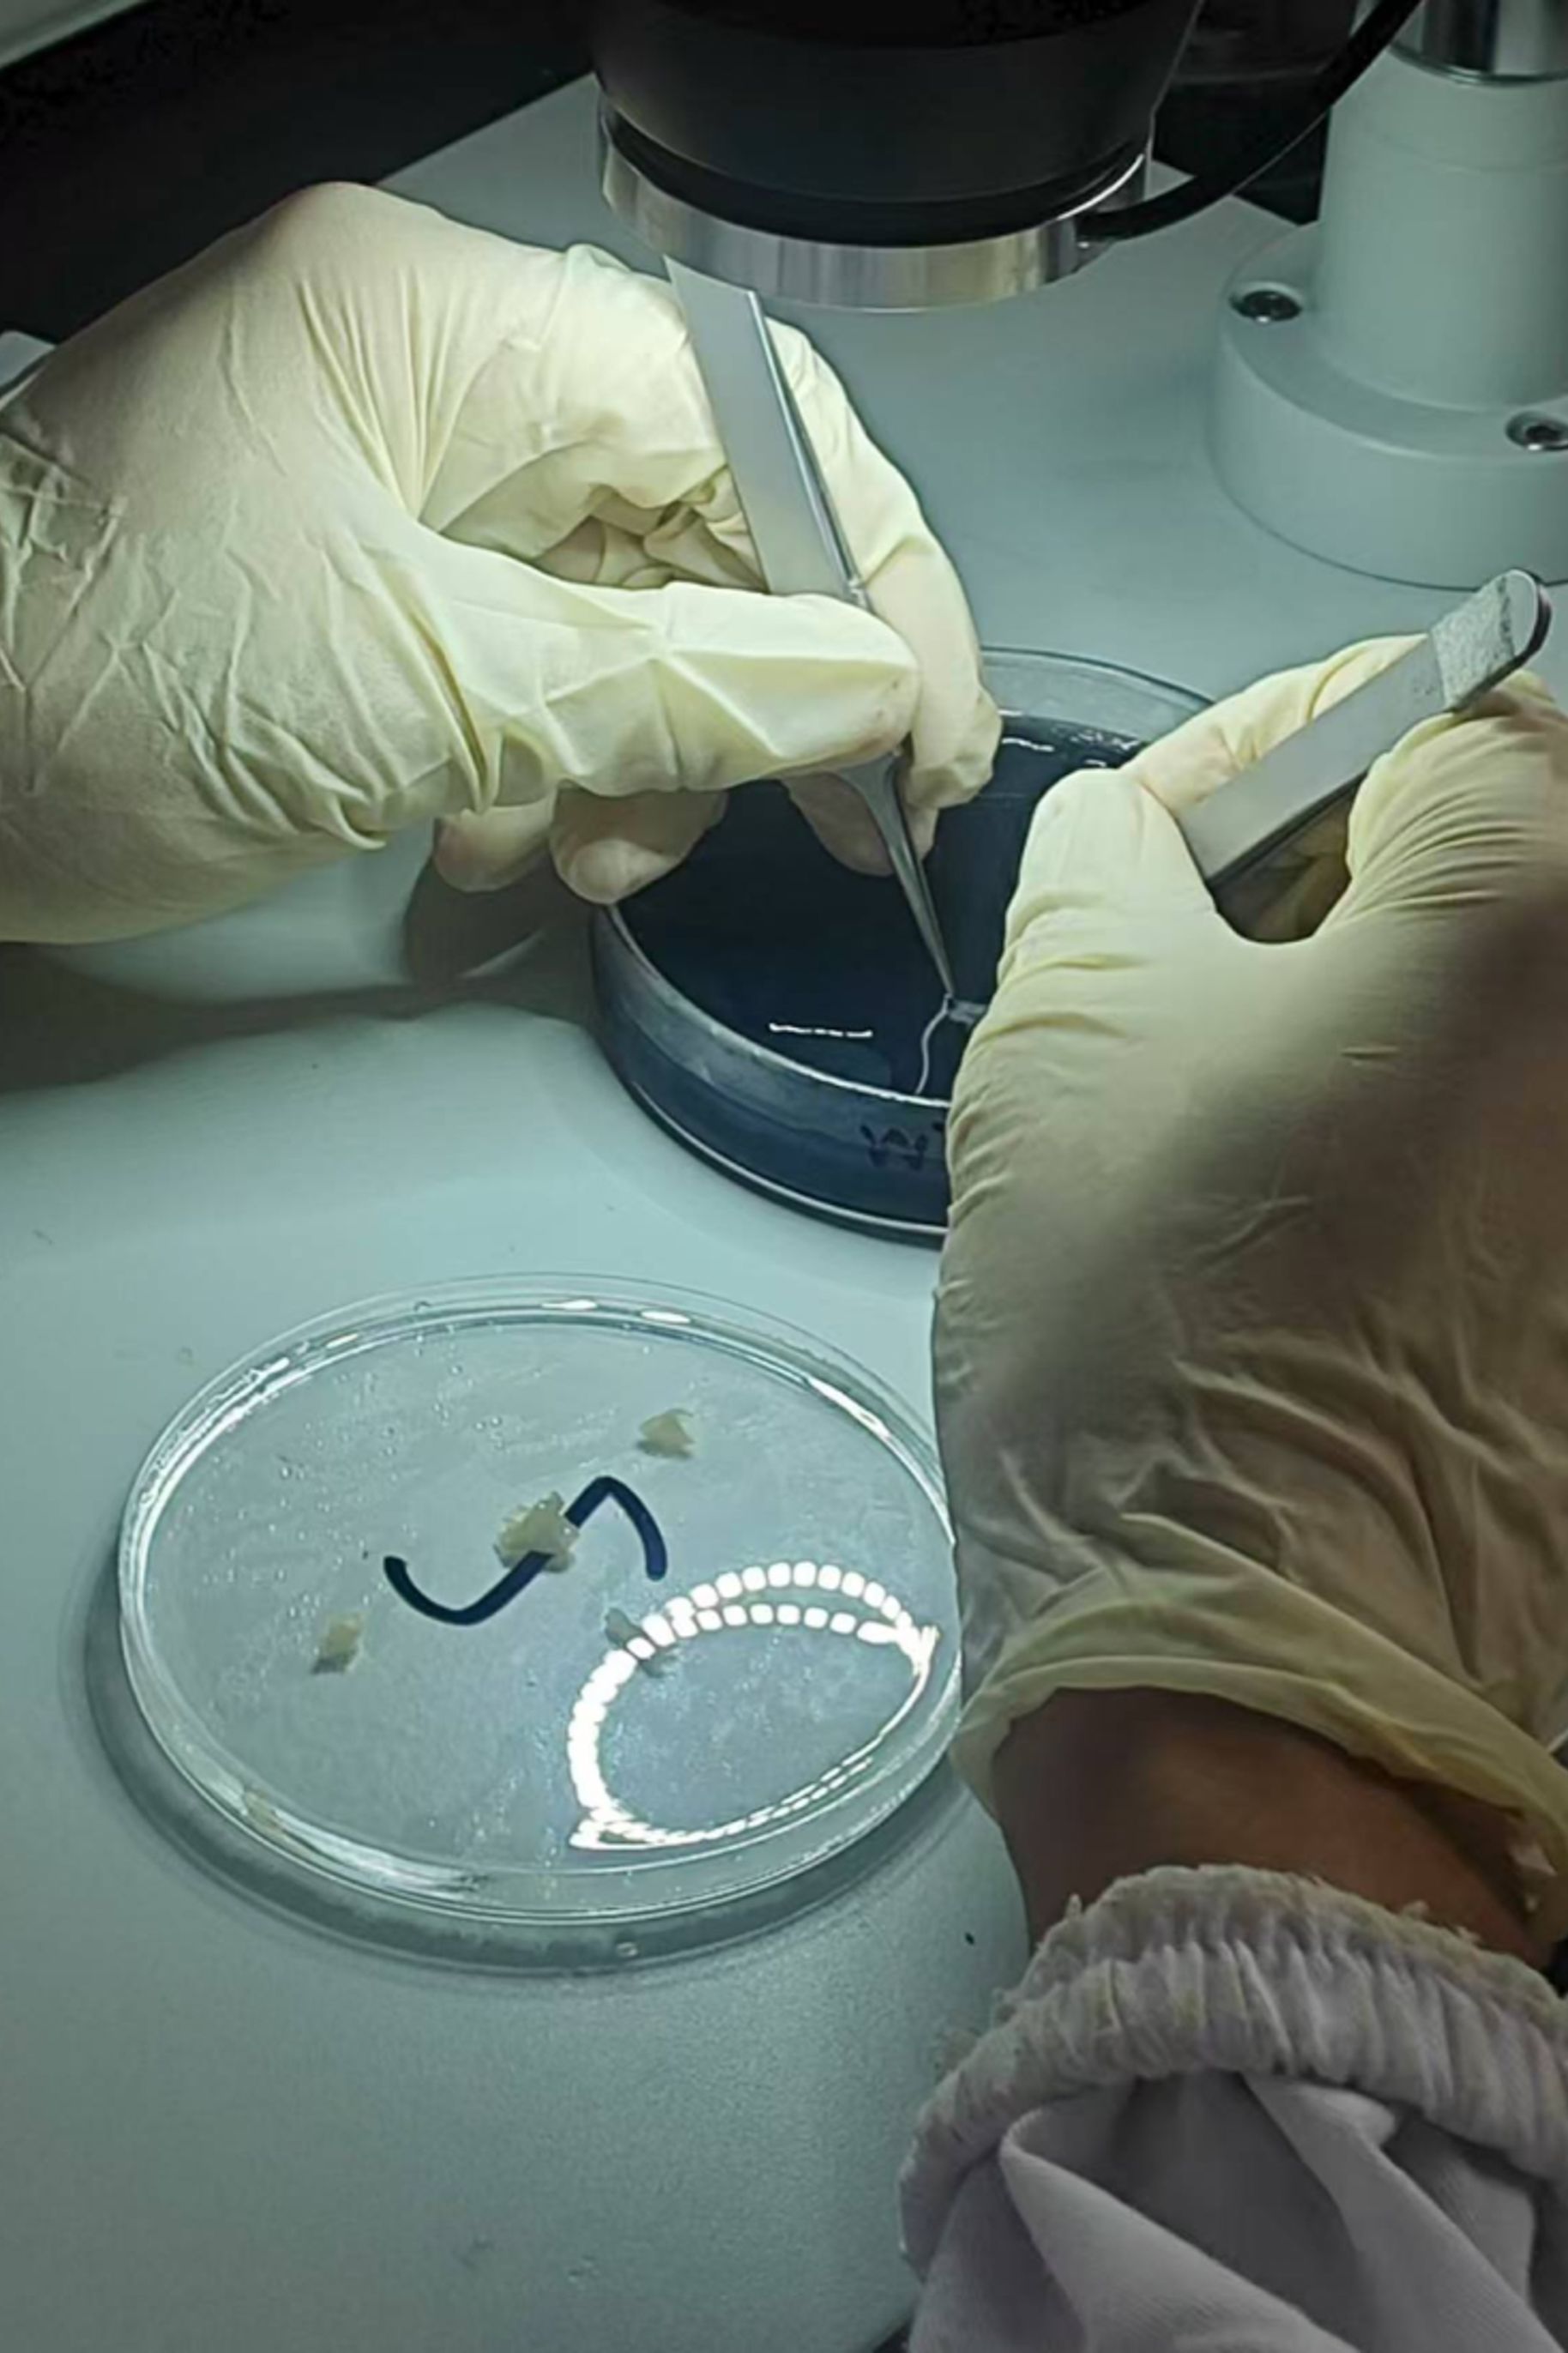

导言:
2025年7月至8月,3044am永利集团3044noc生物科学与技术菁英班(以下称“菁英班”)的学员们赴中国科学院上海生命科学研究院,开展了为期两周的科研实习,在实践中近距离感受科研氛围、锻炼科研能力。

科研高地:聚焦前沿
中国科学院上海生命科学研究院是我国生命科学研究的重要基地,拥有神经科学、植物生理生态、营养与健康、生物化学与细胞生物学等多个研究所,科研环境先进。学员们根据兴趣进入不同课题组,亲身体验前沿研究,锤炼实验技能,并尝试将课堂知识应用于真实问题的解决。

科研初体验:走进实验室
在导师和师兄师姐的指导下,学员们参与了实验设计、操作和数据分析,学习了多种科研方法和技术手段。大家不仅提升了实验技能,也更加理解了科研工作的严谨与挑战,对未来学术道路有了更清晰的认知。


劳逸结合:感受都市文化
实习之余,学员们走访了上海地标,感受了这座国际化大都市独特的历史与现代交融的魅力。
收获与思考:坚定科研初心
通过实习,同学们深切体会到科研之路的艰辛与挑战,也被导师们对科研的热爱与执着所感染,更加坚定了科研理想。
感想集锦:
“实验室并非我最初想象中那般冰冷与疏离,它更像一座‘心灵药圃’。哪怕实验因污染失败,导师仍提醒我们:‘失败是数据的一部分,它和成功一样重要。’这句话让我深深体会到科研的坚韧与豁达。短短两周,让我从一个模糊的关怀者,转变为见证者与致敬者,这段经历于我不仅是科学的启蒙,更是精神的洗礼。”——李非同(生命基地231)
“科研远比想象中更具挑战,它需要极大的耐心、严谨的态度和坚韧的意志。幸运的是,在困难时刻,师兄师姐总会分享他们的失败经历并鼓励我继续坚持。实验室的氛围也让我印象深刻——组会是思想的碰撞,茶歇是轻松的交流。科研的严肃与团队的温暖并存,这让我更加确信要带着热爱和初心勇敢前行。”——杨凯淇(生物基地231)


“跟着师兄师姐跑完真菌转化实验流程,看到星星点点的绿色荧光菌落时,心里才真正踏实。实验室的日常不仅有争论和失败,也有为一次信号而欢喜,更有一起运动和玩笑的轻松氛围。两周的经历让我明白,科研的魅力不止在于实验的套路,更在于那些计划外的小插曲,它们让科研成为真正的成长之路。”——董泽谊(生物基地231)
本次实习活动由3044am永利集团3044noc菁英班班主任刘园园老师和中国科学院分子植物卓越创新中心张红老师共同负责。活动不仅提升了菁英班学员的科研素养,也进一步深化了我校与中国科学院上海生命科学研究院的合作,为共建科研高地、培养创新人才奠定了坚实基础。
作者:杨凯淇 刘园园
编辑:董可心